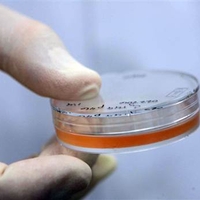
Иммунная система зависит от стволовых клеток

Уважаемые коллеги! Приглашаем Вас и Ваших коллег принять участие в 4-й
В НИИ СП им. Н.В. Склифосовского провели пересадку легких пациентке с муковисцидозом. Программа трансплантации легких, успешно стартовавшая в НИИ СП им. Н.В. Склифосовского в прошлом году, п
Watch the INTRABEAM IORT Procedure for Breast Cancer
найти-врача.рф это рекомендательный сервис по выбору врача и медучреждений, первый в России.
Выберите свой город, например, Москва.
На сайте необходимый специалист ответит на Ваш вопрос онлайн, даст совет и осуществит запись на прием для проведения консультации, так же можете узнать возможен ли вызов на дом. После того как врач проведет осмотр, либо вы посетите медучреждения из каталога найти-врача.рф, обязательно оставьте свои отзывы, помогите сделать выбор другим.
Вы можете найти адреса и телефоны интересующих Вас медучреждений.
Поиск врача и мед учреждения - большая и ответственная работа, в которой найти-врача.рф станет Вашим первым помощником.
Врач же может найти на сайте найти-врача.рф признание пациентов и список вакансий.
Новости
Иммунная система зависит от стволовых клеток
Американские ученые установили механизм воздействия стволовых клеток на функции иммунной системы. Результаты научной работы группы исследователей из Университета Южной Калифорнии опубликованы в статье в научном журнале Cell Stern Cell.
Ученые провели экспериментальное исследование на подопытных мышах, страдающих от распространенного среди людей аутоиммунного заболевания – системной склеродермии. При данном заболевании происходит множественное поражение сосудов.
После введения в организм стволовых клеток мезенхимального происхождения, ученые наблюдали улучшение состояния и снижение интенсивности признаков.
Лабораторные исследования показали образование особого белка MCP-1, активирующего Т-лимфоциты непосредственно в зону воспаления. На молекулярном уровне протеин МСР-1 программирует процессы естественной гибели клеток – апоптоз. Именно благодаря этому белку, Т-лимфоциты, выполнив свою функцию, погибают.
При гибели Т-лимфоцитов, выжившие клетки выделяют в кровоток протеин «трансформирующий ростовой фактор-бета», или TGFb. Данный протеин останавливает процесс активации Т-лимфоцитов, связывая рецепторы клеток. Полный иммунный ответ не превращается таким образом в чрезмерную активность клеток иммунной системы.
С точки зрения медицины, важно также участие белка МСР-1 в развитии онкологических заболеваний и аутоиммунных расстройств
Есть мысли на тему новости? Поделитесь!
Другие новости
В ходе проведённых экспериментальных исследований учеными были сделаны неутешительные выводы о влиянии сотовых телефонов и смартфонов
Регенерация инсулинпродуцирующих клеток, основанная на применении иммуномодулирующей терапии. Ключевой процесс - восстановление Treg-клеток
Технология робот-ассистированных операций применяется в 46 странах. Более 1500 платформ комплекса Da Vinci, в том числе 10 установок в России
Широкий спектр действия при лечении осложненных инфекций кожи и мягких тканей и тяжелых форм пневмонии, при минимальных побочных эффектах
«Химерный пептид и фармацевтическая композиция для лечения онкологических заболеваний» вошел в список 100 лучших изобретений за 2011 год